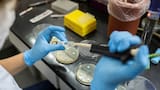
El Malbrán confirmó la detección de tres casos de influenza A (H3N2) del subclado K en la Argentina

Explosión en Beirut: cómo llegó a Líbano la mortal carga de nitrato de amonio que causó la trágica explosión
El nitrato de amonio llevaba seis años en el puerto de la capital libanesa. La explosión de Beirut dejó al menos 137 muertes y más de 5.000 heridos.

¿Cómo llegaron al puerto de Beirut las 2.750 toneladas de nitrato de amonio? Esa es la pregunta que muchos se hacen desde que el presidente de Líbano, Michel Aoun, señalara al nitrato de amonio que llevaba seis años en el puerto de la capital en la explosión que dejó al menos 137 muertes y más de 5.000 heridos.
Y las miradas se han puesto en un hecho acontecido en 2013, cuando un barco arrendado por un ruso y con bandera de Moldavia atracó de emergencia en Beirut por problemas técnicos.
El gobierno no ha dicho que ese sea el origen del nitrato de amonio de la explosión, pero el barco transportaba, precisamente, la cantidad de 2.750 toneladas que fueron confiscadas por las autoridades libanesas.
VIDEO REUTERS
El nitrato de amonio es compuesto que puede ser utilizado como fertilizante pero que también en la fabricación de explosivos.
Si no se almacena en las condiciones adecuadas, como parece ser el caso de lo que había en la capital libanesa, puede resultar muy peligroso.
A pesar de que el director general de Aduanas, Badri Daher y el encargado del puerto, Hassan Koraytem, advirtieron en repetidas ocasiones sobre el peligro que suponía mantener el nitrato de amonio sin las medidas de seguridad requeridas, su llamamiento fue ignorado.
Mientras que la pregunta sobre por qué se descuidó el nitrato de amonio durante seis años parece ser la clave de la investigación, al menos comienza a dilucidarse de dónde pudo proceder el compuesto.

Cómo acabó el nitrato de amonio en el puerto de Beirut
Las 2.750 toneladas de nitrato de amonio que investiga el gobierno libanés es la misma cantidad que las autoridades confiscaron a un buque de carga llamado MV Rhosus en 2013.
El MV Rhosus llevaba la bandera de Moldavia y transportaba el nitrato de amonio desde Georgia hasta Mozambique, pero sufrió problemas técnicos durante la travesía y tuvo que parar en Beirut.
Una vez allí, la nave fue inspeccionada por las autoridades libanesas y se le prohibió reemprender la ruta por no pagar las tarifas portuarias correspondientes, de acuerdo a un reporte de 2015 de Shiparrested, una red de abogados que gestiona asuntos legales de buques de carga.
El antiguo capitán de ese buque, el ruso Boris Prokoshev, fue entrevistado esta semana por la cadena rusa Radio Libertad de Siberia.
Según Prokoshev, la nave pertenecía al ciudadano ruso Igor Grechushkin, el cual se desentendió del asunto y no respondió al llamado de tripulantes y abogados para pagar las tarifas y continuar con la travesía.
Algunos de los tripulantes que iban en el barco fueron liberados, pero el capitán Prokoshev, otro ciudadano ruso y tres ucranianos fueron retenidos.
Posteriormente, la carga de nitrato de amonio fue confiscada por las autoridades y trasladada a un contenedor del puerto por motivos de seguridad.
Shiparrested, que gestionó la liberación de los cuatro tripulantes retenidos, publicó que "la embarcación había sido abandonada por sus dueños".
"Los esfuerzos por ponerse en contacto con los dueños y arrendatarios del barco así como con los compradores de la mercancía para pagar las tasas no fructificaron", reportaron los abogados.
Prokoshev sostiene que Grechushkin aún le debe dinero a él y los tripulantes por los servicios prestados. Sin embargo, sus demandas no han tenido éxito porque este ya no reside en Rusia.
El antiguo capitán también aseguró en la entrevista con Radio Libertad que el barco estaba dañado por falta de mantenimiento y que se hundió después de haber sido liberados.
Por qué nunca se movió el nitrato de amonio del puerto de Beirut
Desde el servicio árabe de la BBC, señalan que dar respuesta a esa pregunta es la clave a la hora de dirimir responsabilidades.
Según Nidale Abou Mrad, periodista de la BBC, muchos libaneses culpan a la corrupción y falta de liderazgo del país, un problema que llevan denunciando desde hace años.
Por su parte, el presidente Aoun prometió que se llevaría a cabo una investigación transparente.
El encargado general del puerto, Hassan Koraytem, y el director de aduanas libanesas, Badri Daher, insisten en que avisaron del peligro del nitrato de amonio almacenado pero que se les ignoró constantemente.
"Requerimos que fuera reexportado pero no ocurrió. Dejamos que los expertos e involucrados determinen por qué", dijo Daher a la cadena libanesa LBCI.
De acuerdo a documentos oficiales, los funcionarios de aduanas enviaron cartas al sistema judicial buscando una solución hasta seis veces entre 2014 y 2017.
A causa de la investigación, el gobierno anunció este miércoles que se había puesto en arresto domiciliario a los encargados de vigilar el nitrato de amonio en el puerto.
Y el Consejo Superior de Defensa de Líbano ha prometido que los responsables se enfrentarán al "máximo castigo posible".
Fuente BBC MUNDO